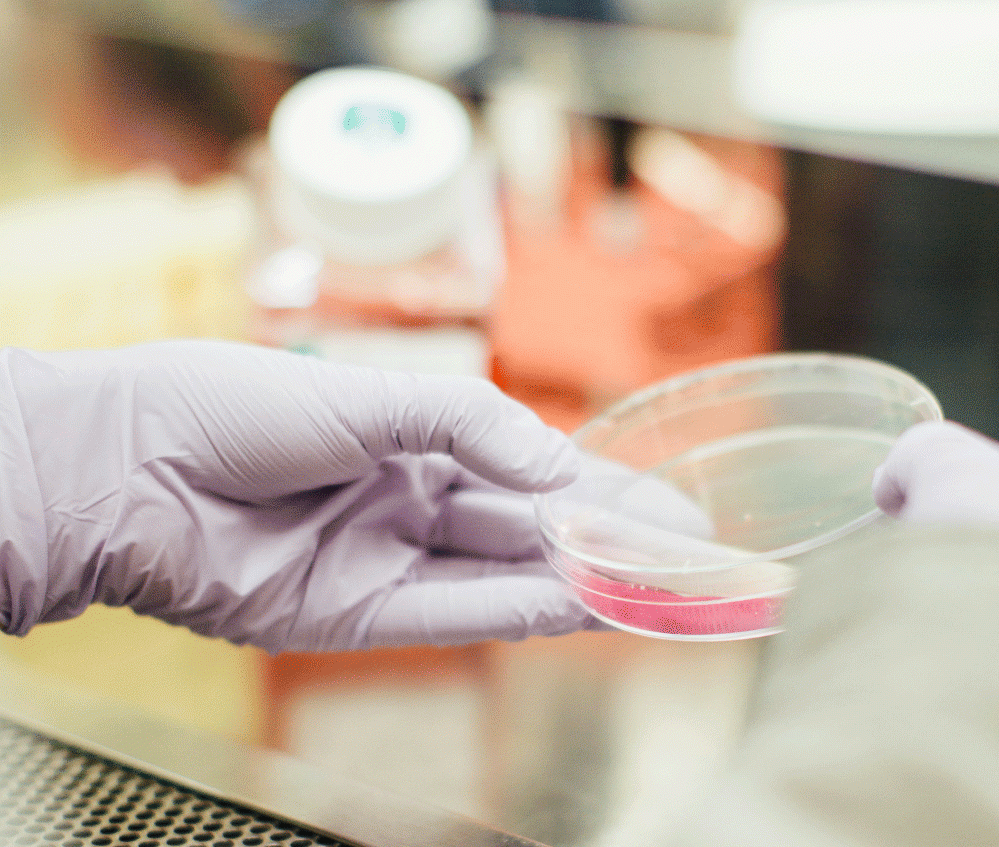
Entwicklung einer Kultivierungsmethode für Prostataorganoide Entwicklung einer Kultivierungsmethode für Prostataorganoide

Entwicklung einer Kultivierungsmethode für Prostataorganoide
Ziel dieses Projektes ist die Etablierung einer Organoidbiobank aus patienten-individuellen Prostatagewebeproben sowie explorative Charakterisierung dieser Prostatakarzinomorganoide. Die Organoidbiobank wird perspektivisch 100 patienten-individuelle Prostatakarzinomorganoide umfassen, welche miMels Gesamt-Exom-Sequenzierung (WES), Durchflusszytometrie und Immunhistochemie auf ihren Tumorgehalt und ihre Eigenschaften als patienten-individuelles Modell geprüft werden. MiMels Prostataorganoiden sollen weiterhin Erkenntnisse aus der Genomsequenzierung funktioniell validiert werden, um auf diese Weise neue Ansatzpunkte für die Therapie des Prostatakarzinoms zu entwickeln.